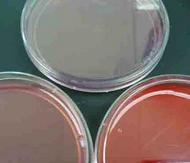

| ||||
Differential & Selective Bacterial Growth Media
Practice Test Questions
Virtual Microbiology Classroom of Science Prof Online
The following questions, from the Virtual Microbiology Classroom, are designed to help students better understand this topic. All questions are based on material that can be found on the Differential & Selective Bacterial Growth Media Lecture Main Page.
These multiple choice and true/false questions are designed to help students better understand this lecture topic.
Page last updated: 2/2016
SPO VIRTUAL CLASSROOMS
 | ||||||
You have free access to a large collection of materials used in a college-level introductory microbiology course. The Virtual Microbiology Classroom provides a wide range of free educational resources including PowerPoint Lectures, Study Guides, Review Questions and Practice Test Questions.
1. MacConkey's agar will only grow bacteria that are....
a. Gram-positive b. Gram-negative
c. Acid-fast
d. halophilic
e. Staph
2. Blood agar can reveal if which species of bacteria is growing:
a. Gram-positive b. Staphylococcus epidermidis
c. Staphylococcus aureus d. Escherichia coli
e. Streptococcus pyogenes
3. The differential aspect of a selective growth medium reveals what about the bacteria growing there? (choose the BEST answer)
b. what it can metabolize (eat / break down)
c. if it is Gram+ or Gram-
d. if it can grow in a salty environment
e. its cell morphology
4. Mannitol Salt agar will only grow bacteria that are:
a. halophiles b. mesophiles c. acidophiles
d. alkilinophiles e. psychrophiles
5. If Mannitol Salt agar is growing bacteria, and the medium itself appears bright yellow, which species of bacteria is growing?
a. Salmonella pullorum
b. Staphylococcus epidermidis
c. Staphylococcus aureus
d. Escherichia coli
e. Streptococcus pyogenes
6. The medium described in question #5 is growing ...
a. normal flora b. a pathogen c. a fungus
d. a Gram-negative microbe
7. Is Blood agar selective, differential, both or neither?
a. selective b. differential c. both d. neither
Bacterial Growth Media Test Questions
8. If MacConkey's agar shows bacterial growth in colorless colonies, what can you know about the bacteria growing?
a. Gram-positive lactose fermenter
b. Gram-negative lactose fermenter
c. Gram-positive non-lactose fermenter
d. Gram-negative non-lactose fermenter
e. the bacteria is selective
9. Blood agar reveals ...
a. bacterial cell wall structure
b. if bacteria has a slime layer
c. if bacteria produces hemolysins
d. if bacteria are selective
e. if bacteria produce lactose
10. If Mannitol Salt agar is growing bacteria, and the medium itself appears pink, which species of bacteria is growing?
a. Salmonella pullorum
b. Staphylococcus epidermidis
c. Staphylococcus aureus
d. Escherichia coli
e. Streptococcus pyogenes